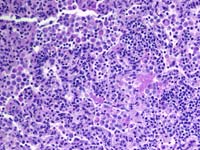

Introdução
Figura 1: Pneumonia por Pneumocystis carinii  Figura 2: Vesícula biliar num caso de Peste Suína Africana  Figura 3: Pulmões de um caso de Peste Suína Clássica Figura 3: Pulmões de um caso de Peste Suína Clássica Figura 4: Rinite grave num caso de Doença de Aujeszky  Figura 5: Gânglios linfáticos traqueobronquiais entumescidos num caso de PCV2  Figura 6: Pulmões de um caso de gripe suína |
Na Europa em geral, a situação no que diz respeito às doenças presentes é muito similar, ainda que haja alguns países que têm problemas com algumas doenças que não existem noutros. Por exemplo, no Reino Unido, só registámos oficialmente (Dez. 2007) a presença do fungo Pneumocystis carinii em porcos de engorda (fig. 1) enquanto que se registou abundantemente noutros países como a Dinamarca durante vários anos.
Assim, os porcos do Reino Unido têm anticorpos para o vírus EMCV (Vírus da encefalomocardite, 20% há uns anos) mas nunca registado manifestações patológicas nem clínicas relacionadas com este vírus.
Vírus
Em primeiro lugar, relativamente aos casos exóticos, todos tratamos de os manter à margem. São um rotundo fracasso, prova disso são a Febre Aftosa (FA) no Reino Unido, ou a Rússia com a Peste Suína Africana (fig. 2) ou em alguns casos somos nós que os geramos, como por exemplo, no Reino Unido com a FA. A Peste Suína Clássica continua a reaparecer no Centro e no Leste da Europa, Alemanha, Hungria e Rússia (fig. 3). A doença de Aujeszky reapareceu recentemente na Roménia (fig. 4) e a Doença Vesicular em Portugal. Por agora não sabemos nada sobre a distribuição dos novos vírus, como o da hepatite E pela Europa ainda sabemos que existe em Espanha e no Reino Unido, mas sem associações definitivas com vírus similares em humanos de modo que até agora não se confirmou uma zoonose.
Em segundo lugar, as doenças virais alteram o equilibrio mas basicamente só há três pelas quais nos temos que preocupar. Trata-se do PRRS, PCV2 (fig. 5) e a Gripe Suína (fig. 6).
Outros vírus encontrados na Europa, por exemplo o PCMV (o antigo vírus da rinite por corpos de inclusão) e o PRCV (coronavirus respiratório) podem ter estirpes de virulência variável através da Europa mas no essencial os vírus são similares.
Em toda a Europa os veterinários podem estar à espera para ver se as campanhas de vacinação para PCV2 demonstram que toda a patologia está relacionada com este agente depois de tudo?, se se tratava em todo o tempo de PRRS?, ou que as causas bacterianas originais estivessem mascaradas pela nossa concentração de PMWS e o PCV2?
O PCV2 e o PRRS destróiem ou deterioram a resposta imunitária de outros agentes de modo que sempre exercem uma influência desestabilizadora dentro da exploração suína. Claro que há variações no vírus PCV2 e no final pode haver diferenças das que todavia não estamos conscientes já que as técnicas moleculares aperfeiçoam-se com o tempo. Estas poderiam chegar a ser capazes de explicar diferenças nas taxas de transmissão, nas taxas de infecção, na patogénese, na virulência e, portanto, nos sinais clínicos, na patologia e no curso da doença.
A Gripe Suína pode ser menos importante devido ao aquecimento global (sobrevive pior em invernos quentes) ou pode ser que a população se tenha adaptado às estirpes H1N1 dos frangos ou ao recombinante H1N2. Pode ser que estejamos todos tão obcecados pelo PCV2 que tenhamos esquecido a importância da gripe suína. Na Europa, a importância relativa dos vírus clássicos H1N1, H3N2 e H1N2 e os vírus H1N1 aviares variam de um país para o outro. No Reino Unido o vírus H1N1 195852 aviar é o mais comum, mas noutros países europeus podem ser os vírus H1N2.
Muitas das antigas doenças víricas reaparecem quando menos se espera. Por exemplo, temos tido casos de TGE (gastroenterite transmisível) em explorações, não onde o vírus da TGE se alterou, mas onde o PRCV que habitualmente se usa para vacinar os animais contra a TGE mutou. Nestes casos, verificámos que as explorações originalmente afectadas na década de 1960 todavia têm vírus TGE mas os leitões continuam protegidos pelo PRCV. O vírus da diarreia epidémica porcina provocará do mesmo modo doenças esporádicas quando mudem as estirpes.

Stan Done. Veterinary Laboratories Agency. Reino Unido



